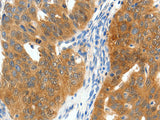
SCN9A Polyclonal Antibody Store at -20°C

SCN9A Polyclonal Antibody Store at -20°C
SKU: E-AB-16052-200
SCN9A Polyclonal Antibody Store at -20°C
| SKU # | E-AB-16052 |
| Reactivity | Human |
| Host | Rabbit |
| Applications | IHC |
Product Details
| Isotype | IgG |
| Host | Rabbit |
| Reactivity | Human |
| Applications | IHC |
| Clonality | Polyclonal |
| Immunogen | Synthetic peptide of human SCN9A |
| Abbre | SCN9A |
| Synonyms | ETHA, GEFSP7, NE NA, NENA, Neuroendocrine sodium channel, PN1, Peripheral sodium channel 1, SCN9A, Scn9a, Sodium, Sodium channel protein type 9 subunit alpha, Sodium channel protein type IX subunit alpha, Sodium channel voltage gated type IX alpha, hNE Na, hNE-Na, hNENa |
| Swissprot | |
| Cellular Localization | Cell membrane. Cell projection. In neurite terminals. |
| Concentration | 0.2 mg/mL |
| Buffer | Phosphate buffered solution, pH 7.4, containing 0.05% stabilizer and 50% glycerol. |
| Purification Method | Affinity purification |
| Research Areas | Cancer, Metabolism, Neuroscience, Signal Transduction |
| Conjugation | Unconjugated |
| Storage | Store at -20°C Valid for 12 months. Avoid freeze / thaw cycles. |
| Shipping | The product is shipped with ice pack,upon receipt,store it immediately at the temperature recommended. |
Related Reagents
| Applications | Recommended Dilution |
| IHC | 1:50-1:200 |
Background
This gene encodes a voltage-gated sodium channel which plays a significant role in nociception signaling. Mutations in this gene have been associated with primary erythermalgia, channelopathy-associated insensitivity to pain, and paroxysmal extreme pain disorder.